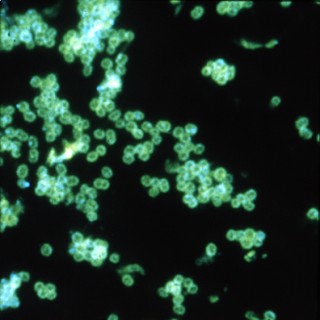

Podcasts about Neisseria
- 61PODCASTS
- 103EPISODES
- 25mAVG DURATION
- 1EPISODE EVERY OTHER WEEK
- May 14, 2026LATEST
POPULARITY
Best podcasts about Neisseria
Latest news about Neisseria
- Phenotypic and Genomic Characterization of Antimicrobial-Resistant Neisseria gonorrhoeae of Public Health Concern Emerging Infectious Diseases Journal - May 27, 2026
- CARB-X awards funding to AdJane to advance its nOMV platform-derived vaccine for the prevention of gonorrhea Montreal Gazette - Apr 28, 2026
- Modular Synthesis of Neisseria meningitidis Lipooligosaccharide Inner Core Oligosaccharide Library to Identify Broadly Reactive Antigenic Epitopes Wiley: Angewandte Chemie International Edition: Table of Contents - Apr 9, 2026
- Recent outbreaks highlight the risks of bacterial meningitis – and the need to vaccinate Health – The Conversation - Apr 8, 2026
- Structural insights into the mechanism underpinning iron piracy in pathogenic Neisseria | Science Advances AAAS: Science Advances: Table of Contents - Apr 3, 2026
- Couples share 30% of their gut bacteria. Here’s how that may affect health English – The Conversation - Mar 23, 2026
- Two people have died from bacterial meningitis in the UK. An expert answers your questions The Conversation – Articles (UK) - Mar 16, 2026
- New antibiotic could stave off drug-resistant gonorrhoea New Scientist - Technology - Dec 11, 2025
- We live in the luckiest timeline LessWrong - Nov 12, 2025
- WHO warns of widespread resistance to common antibiotics worldwide News (English) - World Health Organization - Oct 13, 2025
Latest podcast episodes about Neisseria
In this episode of Let's Talk Micro, we close out our gram-negative cocci series by talking about the "background singers" of the group—the organisms that quietly show up on respiratory cultures and oral flora plates every day. We explore the world of non-pathogenic Neisseria species, along with rod-shaped and coccobacillary Neisseria and Moraxella that break the classic gram-negative diplococci rule. From commensals and opportunistic pathogens to their role in respiratory cultures and bench identification, this episode focuses on how to think through these isolates in the clinical microbiology laboratory. As always, we tie it back to the bench—because sometimes the organisms sitting quietly in the background still matter. Stay connected with Let's Talk Micro: Website: letstalkmicro.com Questions or feedback? Email me at letstalkmicro@outlook.com Interested in being a guest on Let's Talk Micro? Fill out the form here: https://forms.gle/V2fT3asjfyusmqyi8 Support the podcast: Venmo Buy me a Ko-fi
This episode reviews four recently published studies about the impact of doxycycline post-exposure prophylaxis (doxy PEP) on Neisseria gonorrhoeae isolates with tetracycline resistance, Staphylococcus aureus, Group A streptococcus, and syphilis. View episode transcript and references at www.std.uw.edu.This podcast is dedicated to an STD [sexually transmitted disease] review for health care professionals who are interested in remaining up-to-date on the diagnosis, management, and prevention of STDs and STIs. Editor and host Dr. Meena Ramchandani is an Assistant Professor of Medicine at the University of Washington (UW), Program Director of the UW Infectious Diseases Fellowship Program, and Associate Editor of the National STD Curriculum.
230: Same Gram Stain, Different Story: Neisseria meningitidis vs gonorrhoeae
In this week's episode, we continue our series on gram-negative cocci and take a closer look at two of the most important organisms: Neisseria meningitidis and Neisseria gonorrhoeae. On the Gram stain, they may look the same—but clinically, they represent very different scenarios. We walk through colonization, transmission, and key virulence factors, and connect them to the infections they cause—from meningitis and invasive disease to mucosal and disseminated gonococcal infections. We also bring it back to the bench, discussing specimen source, testing approaches like NAAT and culture, and how to think through these organisms in real-world laboratory settings. Looking to stay up to date with the latest clinical microbiology resources? Check out Wiley's ClinMicroNow—bringing trusted ASM Press content into one powerful, searchable platform :
In this episode we continue our gram-negative cocci series by moving beyond the plate and into modern identification methods. From traditional systems like VITEK and RapID NH to MALDI-TOF and molecular testing, we explore how these organisms are identified in today's clinical microbiology lab. We also break down the role of NAATs and syndromic panels in detecting organisms like Neisseria meningitidis and Neisseria gonorrhoeae, especially in situations where culture may be delayed or negative. This episode focuses on how these tools fit into real-world workflows—highlighting their advantages, limitations, and how to interpret results at the bench. Stay connected with Let's Talk Micro: Website: letstalkmicro.com Questions or feedback? Email me at letstalkmicro@outlook.com Interested in being a guest on Let's Talk Micro? Fill out the form here: https://forms.gle/V2fT3asjfyusmqyi8 Support the podcast: Venmo Buy me a Ko-fi
228: Gram-Negative Cocci: What to Do After the Gram Stain
In this episode of Let's Talk Micro, we continue our gram-negative cocci series by focusing on what to do after the Gram stain. You've identified gram-negative cocci—now what? We take a practical, bench-focused approach to working these organisms up, covering key culture media like blood agar, chocolate agar, and selective media such as Modified Thayer-Martin and Martin-Lewis. We also review collection and transport considerations, including JEMBEC and CO₂ requirements for Neisseria gonorrhoeae. We then dive into commonly used tests, including ONPG for differentiating Neisseria lactamica and Neisseria meningitidis, the CTA test and its limitations, and the butyrate esterase test for identifying Moraxella catarrhalis. This episode is all about building confidence at the bench—connecting what you see to what you do next. Stay connected with Let's Talk Micro: Website: letstalkmicro.com Questions or feedback? Email me at letstalkmicro@outlook.com Interested in being a guest on Let's Talk Micro? Fill out the form here: https://forms.gle/V2fT3asjfyusmqyi8 Support the podcast: Venmo Buy me a Ko-fi
227: When Gram-Negative Cocci Show Up: How to Think at the Bench
In this episode of Let's Talk Micro, we kick off a new series on gram-negative cocci by starting where it all begins—the Gram stain. Seeing gram-negative diplococci on a smear can feel intimidating, especially when you're on the bench and need to make the right call. In this episode, we focus on how to approach that moment with confidence. We walk through the key organisms you'll encounter, including Neisseria, Moraxella, and Veillonella, and discuss how morphology, specimen source, and clinical context all come together to guide your thinking. We also revisit a correction from a previous episode regarding carbohydrate utilization in Neisseria species. This episode is all about building a strong foundation—how to think before jumping to identification. Stay tuned for the next episode, where we'll dive into the media and tests used to identify these organisms in the lab. Stay connected with Let's Talk Micro: Website: letstalkmicro.com Questions or feedback? Email me at letstalkmicro@outlook.com Interested in being a guest on Let's Talk Micro? Fill out the form here: https://forms.gle/V2fT3asjfyusmqyi8 Support the podcast: Venmo Buy me a Ko-fi
Meningitis + Science News Webinar from 3/25/26
Tom opens this week's livestream with an announcement about a new community platform launching in early May 2026 through New Biology Clinic and DrTomCowan.com. -New Biology Clinic members at any level will be included at no extra charge. -Graduates of the New Biology curriculum will receive a trial membership. -Tom shares that the goal is to help like-minded people connect online first, then build real in-person friendships, local relationships, and practitioner support. -He also ties this initiative to the upcoming New Biology Experience at Polyface Farm in June, describing it as part of a broader effort to bring people together in community.New Biology Experience link here.Highlights from this session include: -Tom shares several pieces of “science news,” including a story about a python blood molecule being studied as a possible appetite suppressant, which he uses to mock the logic behind new obesity drug development. -He comments on a report claiming that a third of Americans believe in an impending apocalypse, pointing to what he sees as a contradiction between welcoming doomsday and wanting institutions to prevent it. -Tom reads and analyzes a comment from Australian microbiologist Christopher Peacock, focusing on Peacock's claim that the “only difference” in viral plaque assays is the presence or absence of the virus. Tom argues that such a statement would require prior purification of the virus from the sample, which he says virologists themselves claim is not possible. -The main topic of the session is meningitis, especially the claim that Neisseria meningitidis causes meningitis and septicemia. Tom reviews a scientific paper on meningococcal pathogenesis and argues that the theory fails because the bacteria are commonly found in healthy people, while actual illness is rare. -He highlights what he sees as a major weakness in the mainstream explanation: the researchers themselves admit that the mechanisms by which the bacteria move from harmless colonization in the nose to life-threatening disease remain largely unexplained. -Tom argues that the theory becomes increasingly speculative, shifting from bacteria, to subtypes, to genetic differences, to signaling pathways, instead of proving direct causation. -He also notes that there is no convincing animal model for meningococcal sepsis or meningitis and says this undermines the claim that the bacteria are the true cause. -In discussing a recent teen meningitis case, Tom speculates that vaping-related toxins such as nicotine, propylene glycol, heavy metals, and carcinogens may be a more plausible contributor to brain and tissue damage than the bacteria themselves. -He closes by arguing that meningitis vaccine campaigns are built on flawed reasoning and by reaffirming his challenge to Christopher Peacock to produce proof that a virus was isolated before cell culture.Support the showWebsites:https://drtomcowan.com/https://www.drcowansgarden.com/https://newbiologyclinic.com/https://newbiologycurriculum.com/Instagram: @TalkinTurkeywithTomFacebook: https://www.facebook.com/DrTomCowan/Bitchute: https://www.bitchute.com/channel/CivTSuEjw6Qp/YouTube: https://www.youtube.com/channel/UCzxdc2o0Q_XZIPwo07XCrNg
2024 STI Prevention Conference: Neisseria Gonorrhea Prevalence and Novel Treatment and Prevention Medications
This episode reviews five oral abstracts on the prevalence of antimicrobial-resistant Neisseria Gonorrhea globally and in the US; clinical trial results of two novel oral antibiotics; and the protective effect of a meningococcal vaccine. These abstracts were presented at the 2024 STI Prevention Conference. View the abstracts in the 2024 STI Prevention Conference Abstract Book. View episode transcript at www.std.uw.edu.This podcast is dedicated to an STD [sexually transmitted disease] review for health care professionals who are interested in remaining up-to-date on the diagnosis, management, and prevention of STDs and STIs. Editor and host Dr. Meena Ramchandani is an Assistant Professor of Medicine at the University of Washington (UW), Program Director of the UW Infectious Diseases Fellowship Program, and Associate Editor of the National STD Curriculum.
On episode #94 of the Infectious Disease Puscast, Daniel and Sara review the infectious disease literature for the weeks of 11/11/25 – 11/19/25. Host: Daniel Griffin and Sara Dong Subscribe (free): Apple Podcasts, RSS, email Become a patron of Puscast! Links for this episode Viral Epstein-Barr virus reprograms autoreactive B cells as antigen-presenting cells in systemic lupus erythematosus (Science Translational Medicine) Hepatitis B reactivation following switch away from tenofovir-containing anti-retroviral therapy in people living with HIV: A case series and lessons for practice (CID) Antimicrobial drug-resistant Neisseria gonorrhoeae (GC) infections in men using doxycycline postexposure prophylaxis. A substudy of the ANRS 174 DOXYVAC trial (CID) HIV Pre-exposure Prophylaxis Does Not Increase Gonorrhea and Chlamydia Incidence in Young Black and Hispanic Men who Have Sex With Men: An Observational Cohort Study (OFID) Bacterial Global and regional knowledge of antibiotic use and resistance among the general public: a systematic review and meta-analysis (CMI: Clinical Microbiology and Infection) Infant Botulism Outbreak Linked to Infant Formula, November 2025 (CDC: Botulism) Outbreak Investigation of Infant Botulism: Infant Formula (November 2025) (FDA) Vitamin D deficiency at hospital admission with community-acquired pneumonia is associated with increased risk of mortality: A Prospective Cohort Study (OFID) Bat-Associated Hemotropic Mycoplasmas in Immunosuppressed Children, Spain, 2024 (Emerging Infectious Diseases) A Multicomponent Intervention to Improve Maternal Infection Outcomes (NEJM) Fungal The Last of US Season 2 (YouTube) Increasing Fluconazole Resistance in Candida parapsilosis: A 10-Year Analysis of Blood Culture Isolates at a US Reference Laboratory (2015–2024) (JID) British Society for Medical Mycology best practice recommendations for the diagnosis of serious fungal diseases: 2025 update (LANCET: Infectious Diseases) In Vivo Evolution of Candida auris Multidrug Resistance in a Patient Receiving Antifungal Treatment (JID) Parasitic Implications of a fatal anaphylactic reaction occurring 4 hours after eating beef in a young man with IgE antibodies to galactose-α-1,3-galactose (JACI: Journal of Allergy and Clinical Immunology In practice) WHO recommends R21/Matrix-M vaccine for malaria prevention in updated advice on immunization (WHO) Effectiveness of the RTS,S/AS01E malaria vaccine in a real-world setting over 1 year of follow-up after the three-dose primary schedule: an interim analysis of a phase 4 study in Ghana, Kenya, and Malawi (LANCET: Global Health) A systematic review and an individual patient data meta-analysis of ivermectin use in children weighing less than fifteen kilograms: Is it time to reconsider the current contraindication? (PLoS Neglected Tropical Diseases) Miscellaneous IL12RB1 deficiency appearing in North America: expanding the clinical phenotypes (CID) Music is by Ronald Jenkees Information on this podcast should not be considered as medical advice.
Antimicrobial resistance (AMR) continues to grow as a global health threat, making infections harder to treat and leaving fewer options for patients. The need for new antibiotics is an urgent matter — but traditional discovery methods are slow and limited. In this episode of Let's Talk Micro, Luis is joined by Dr. James Collins, professor at MIT and researcher at the Broad Institute, who is leading efforts to apply AI to antibiotic discovery. We discuss how his team used deep learning to uncover promising new compounds, including NG1 and DN1, which showed activity against drug-resistant Neisseria gonorrhoeae and Staphylococcus aureus. We also talk about the challenges of bringing discoveries from computer models to the clinic, and what this approach could mean for the future of the fight against superbugs. Link to study: https://www.cell.com/cell/abstract/S0092-8674%2825%2900855-4 Check out the website: https://www.letstalkmicro.com/ Questions? Feedback? Send those to letstalkmicro@outlook.com Want to support the podcast? Here's how: Venmo: https://venmo.com/u/letstalkmicro Buy me a Ko-fi: https://ko-fi.com/letstalkmicro
Check-up Semanal #204: Doença de Parkinson, vacina meningocócica e mais!
Confira os temas do Check-up Semanal de hoje: Diretriz brasileira para tratamento de sintomas não motores na doença de Parkinson; Fezolinetant e elinzanetant no tratamento dos sintomas vasomotores da menopausa; CROI 2025: Tecovirimat é eficaz no tratamento de mpox?; Atualização: Quais são as recomendações do novo consenso sobre BIA-ALCL?; FDA aprova vacina meningocócica contra 5 sorotipos de Neisseria meningitidis. Ouça agora!
On episode #85 of the Infectious Disease Puscast, Daniel and Sara review the infectious disease literature for the weeks of 7/3 – 7/21/25. Hosts: Daniel Griffin and Sara Dong Subscribe (free): Apple Podcasts, RSS, email Become a patron of Puscast! Links for this episode Viral Elimination of HIV Reservoirs Harboring Intact Proviruses (JID) Bacterial Expansion of tetM-Carrying Neisseria gonorrhoeae in the United States, 2018–2024 (NEJM) Study hints doxyPEP use coincides with rise in tetracycline-resistant gonorrhea in US (CIDRAP) Potential Impact of Doxycycline Post-Exposure Prophylaxis on Tetracycline Resistance in Neisseria gonorrhoeae and Colonization With Tetracycline-Resistant Staphylococcus aureus and Group A Streptococcus (CID) Methenamine hippurate asprophylaxis for recurrent urinary tract infections in older women – a triple-blind, randomised, placebo-controlled, phase IV trial (ImpresU). (CMI: Clinical Microbiology and Infection) Diagnosis and Management ofCommunity-acquired Pneumonia(American Journal of Respiratory and Critical Care Medicine) Complicated Urinary Tract Infections (cUTI): Clinical Guidelines for Treatment and Management (IDSA) The impact of an intervention to increase follow-up blood cultures for patients with Staphylococcus aureus bacteriuria (Antimicrobial Stewardship & Healthcare Epidemiology) Fungal The Last of US Season 2 (YouTube) Candida auris Containment Responses in Health Care Facilities that Provide Hemodialysis Services (CDC: MMWR) Candidozyma auris: an emerging threat (Reflections on Infectious Prevention and Control) Effects of postoperative antifungal therapy on the recurrence of Aspergillus infection after pulmonary aspergilloma resection (BMC Infectious Diseases) Triazole-resistant Aspergillus fumigatus in the Netherlands between 1994 and 2022: a genomic and phenotypic study (LANCET: Microbe) Large language models and their performance for the diagnosis of histoplasmosis (PLoS Neglected Tropical Diseases) Parasitic Field evidence of Trypanosoma cruzi infection, diverse host use and invasion of human dwellings by the Chagas disease vector in Florida, USA (PLoS Neglected Tropical Diseases) Music is by Ronald Jenkees Information on this podcast should not be considered as medical advice.
Antimicrobial Resistance in Neisseria Gonorrhoeae: Surveillance Programs
Microbiologist and Associate Professor at the University of Washington Dr. Olusegun Soge reviews four U.S. based surveillance programs: GISP, eGISP, SURGG, and CARGOS – the umbrella program rolled out in August 2024. Dr. Soge and National STD Curriculum Podcast Host Dr. Meena Ramchandani also discuss a vaccine and another STI pathogen developing resistance. View episode transcript and references at www.std.uw.edu.This podcast is dedicated to an STD [sexually transmitted disease] review for health care professionals who are interested in remaining up-to-date on the diagnosis, management, and prevention of STDs. Editor and host Dr. Meena Ramchandani is an Assistant Professor of Medicine at the University of Washington (UW), Program Director of the UW Infectious Diseases Fellowship Program, and Associate Editor of the National STD Curriculum.
Antimicrobial Resistance in Neisseria Gonorrhoeae: Key Microbiologic Factors
Microbiologist and Associate Professor at the University of Washington Dr. Olusegun Soge reviews six different ways that the microbiology of Neisseria gonorrhoeae contributes to its antimicrobrial resistance. Dr. Soge and National STD Curriculum Podcast Host Dr. Meena Ramchandani then explore how current overuse and misuse of antibiotics in the STI field might be part of the problem. View episode transcript at www.std.uw.edu.This podcast is dedicated to an STD [sexually transmitted disease] review for health care professionals who are interested in remaining up-to-date on the diagnosis, management, and prevention of STDs. Editor and host Dr. Meena Ramchandani is an Assistant Professor of Medicine at the University of Washington (UW), Program Director of the UW Infectious Diseases Fellowship Program, and Associate Editor of the National STD Curriculum.
Antimicrobial Resistance in Neisseria Gonorrhoeae: Past, Present, and Future
CDC and the World Health Organization consider Neisseria gonorrhoeae an urgent antibiotic-resistant threat because it continuously develops resistance. Microbiologist and Associate Professor at the University of Washington Dr. Olusegun Soge provides a historical overview of past efforts, an update on the current situation, why global surveillance is so important, and a potential new treatment for uncomplicated gonorrhea. View episode transcript at www.std.uw.edu.This podcast is dedicated to an STD [sexually transmitted disease] review for health care professionals who are interested in remaining up-to-date on the diagnosis, management, and prevention of STDs. Editor and host Dr. Meena Ramchandani is an Assistant Professor of Medicine at the University of Washington (UW), Program Director of the UW Infectious Diseases Fellowship Program, and Associate Editor of the National STD Curriculum.
Épisode 153 – Chlamydia et gonorrhée: les invités qu'on ne veut pas laisser entrer! – Partie 2
Un nouvel épisode du Pharmascope est disponible! Dans ce 153e épisode, Nicolas, Isabelle et Olivier discutent de chlamydia et de gonorrhée. Cette deuxième partie est consacrée au traitement de ces infections. Les objectifs pour cet épisode sont les suivants: Discuter de la prise en charge de la chlamydia et de la gonorrhée. Discuter des traitements antibiotiques de la chlamydia et de la gonorrhée. Discuter de l'utilisation de la DOXY-PEP. Ressources pertinentes en lien avec l'épisode Agence de la santé publique du Canada. Chlamydia, gonorrhée et syphilis infectieuse au Canada : Données de surveillance de 2021. INESSS. Guide d'usage optimal : Infection confirmée à Chlamydia trachomatis ou à Neisseria gonorrhoeae. Septembre 2024. INESSS. Guide d'usage optimal : Approche syndromique. Décembre 2024. Portail VIH/sida du Québec : Notification anonyme des partenaires. MSSS. Traitement accéléré des partenaires pour les infections à Chlamydia trachomatis et à Neisseria gonorrhoeae - Aide-mémoire pour les cliniciens. Juillet 2021. MSSS. Traitement accéléré des partenaires pour les infections à Chlamydia trachomatis et à Neisseria gonorrhoeae - Aide-mémoire pour les pharmaciens. Juillet 2021. MSSS. Carte de notification chlamydia/gonorrhée. Juillet 2021. Páez-Canro C et coll. Antibiotics for treating urogenital Chlamydia trachomatis infection in men and non-pregnant women. Cochrane Database Syst Rev. 2019 Jan 25;1(1):CD010871. Lau A et coll. Azithromycin or Doxycycline for Asymptomatic Rectal Chlamydia trachomatis. N Engl J Med. 2021 Jun 24;384(25):2418-2427. Bížová B et coll. Single-dose cefixime 800 mg plus doxycycline 100 mg twice a day for 7 days compared with single-dose ceftriaxone 1 g plus single-dose azithromycin 2 g for treatment of urogenital, rectal, and pharyngeal gonorrhoea: a randomised clinical trial. Clin Microbiol Infect. 2024 Feb;30(2):211-215. Nguyen PTT et coll. Randomized controlled trial of the relative efficacy of high-dose intravenous ceftriaxone and oral cefixime combined with doxycycline for the treatment of Chlamydia trachomatis and Neisseria gonorrhoeae co-infection. BMC Infect Dis. 2022 Jul 9;22(1):607. Yang KJ et coll. Effectiveness of Cefixime for the Treatment of Neisseria gonorrhoeae Infection at 3 Anatomic Sites: A Systematic Review and Meta-Analysis. Sex Transm Dis. 2023 Mar 1;50(3):131-137. Kirkcaldy RD et coll. The efficacy and safety of gentamicin plus azithromycin and gemifloxacin plus azithromycin as treatment of uncomplicated gonorrhea. Clin Infect Dis. 2014 Oct 15;59(8):1083-91. Bachmann LH, Barbee LA, Chan P, et colll. CDC Clinical Guidelines on the Use of Doxycycline Postexposure Prophylaxis for Bacterial Sexually Transmitted Infection Prevention, United States, 2024. MMWR Recomm Rep. 2024;73(2):1-8.
The Mind-Mouth Connection: How Oral Bacteria Impacts Your Brain
Story at-a-glance Research found that higher levels of harmful bacteria (Prevotella intermedia) in the mouth are linked to cognitive impairment, while beneficial bacteria (Neisseria and Haemophilus) support better brain function Nitric oxide production by beneficial oral bacteria plays a crucial role in maintaining blood flow to the brain. Nitrate-rich vegetables help boost the population of these healthy bacteria People with the APOE4 gene show a distinct oral microbiome composition. Research shows they have lower levels of Neisseria bacteria and higher amounts of Prevotella, which is associated with increased dementia risk Harmful oral bacteria have the ability to enter the bloodstream and cross the blood-brain barrier, leading to brain inflammation that results in cognitive decline Maintaining oral health through proper diet, regular brushing and flossing, nose breathing, avoiding antibacterial mouthwash and practicing oil pulling are effective strategies against cognitive decline
Hosts: Jake Lancaster MD, Chief Medical Information Officer and Amanda Comer DNP, System Director, Advanced Practice ProvidersGuest: Alex Yoby, PharmacistCME Credit Info:Link to complete brief survey and claim CME credit: https://www.surveymonkey.com/r/C55LKSYCME credit is available for up to 3 years after the stated release dateContact CEOD@bmhcc.org if you have any questions about claiming credit.CDC's Sexually Transmitted Infections (STI) TreatmentGuidelines, 2021Notable updates:These guidelines discuss 1) updated recommendations fortreatment of Neisseria gonorrhoeae, Chlamydia trachomatis, andTrichomonas vaginalis; 2) addition of metronidazole to the recommendedtreatment regimen for pelvic inflammatory disease; 3) alternative treatmentoptions for bacterial vaginosis; 4) management of Mycoplasma genitalium;5) human papillomavirus vaccine recommendations and counseling messages; 6) expanded risk factors for syphilis testingamong pregnant women; 7) one-time testing for hepatitis C infection; 8)evaluation of men who have sex with men after sexual assault; and 9) two-steptesting for serologic diagnosis of genital herpes simplex virusSyphilis LoreIt is postulated that syphilis came to Europe in the 1490s when Columbusarrived in Italy from America. After Italy surrendered to the invading Frenchin 1495, this new disease rapidly spread across Europe. The name"syphilis" comes from the work of Girolamo Fracastoro, a noted poetand physician in Verona, Italy. In 1530, he wrote about a shepherd namedSyphilus who angered Apollo, causing the god to curse the entire populationwith the affliction that we now know as syphilisT. pallidumSyphilis is a systemic, bacterial infection caused byTreponema pallidum. Treponema are thin,Gram-negative, slowly metabolizing spirochetal bacterium, requiring an averageof 30 hours to multiply. It is microaerophilic and cannot grow on standardculture media. Treponema pallidum's outer membrane lacks lipopolysaccharidesand has few surface-exposed unique proteins, making it difficult for the immunesystem to fight the infection. Because of this characteristic, Tpallidum is labeled as a stealth pathogen. T. pallidum is theonly Treponema species that causes sexually transmitted disease.Syphilis is characterized by a wide range of variableclinical symptoms that can resemble other diseases, which make it difficult todiagnose without a test, therefore, it is often referred to as “The GreatImitator”. The infection progresses through multiple stages (primary,secondary, latent, and tertiary) and can affect virtually every organ system inthe body, even many years or even decades after the original infection.Infected people are contagious during the primary and secondary stages ofsyphilis.Stages of syphilisPrimary syphilis: Primary syphilis classicallypresents as a single painless ulcer or chancre at the site of infection but canalso present with multiple, atypical, or painful lesions. A chancre is definedas a firm, round, painless ulcer at the...
Today we will discuss if screening asymptomatic Men who have sex with Men, also referred to as MSM, who are receiving HIV pre-exposure anti-retroviral medication, called HIV PrEP, routinely for bacterial STIs, gonorrhoea and chlamydia through pharyngeal, urine and rectal PCR testing every three months- also referred to as 3x3 testing is indeed of benefit or may cause harm. This year, in Lancet HIV, the Gonoscreen trial, a randomised controlled trial, of 500 MSM on PrEP in each arm followed up for 12 months reported that 3x 3 testing does not reduce the incidence of gonorrhoea and chlamydia infections in this specific cohort. In Belgium, this trial has led to a change in clinic practice through the Belgium HIV PrEP guidelines where patients will be screened less frequently and intensely. Lancet ID on the other hand published an opinion piece by Raccagni et al where concerns about transmission and morbidity risk of untreated infection and implications of using poor quality screening tools are voiced. We will discuss today the merit of the Gonoscreen trial and other studies that support a decrease in screening & treating asymptomatic bacterial STIs and exercising stricter antimicrobial stewardship versus the risks associated with leaving asymptomatic infections untreated and risking morbidity and transmission. Relevant links: Effect of screening for Neisseria gonorrhoeae and Chlamydia trachomatis on incidence of these infections in men who have sex with men and transgender women taking HIV pre-exposure prophylaxis (the Gonoscreen study): results from a randomised, multicentre, controlled trial Primum non-nocere: Is it time to stop screening for Neisseria gonorrhoeae and Chlamydia trachomatis in men who have sex with men taking HIV pre-exposure prophylaxis? The arrested immunity hypothesis in an immunoepidemiological model of Chlamydia transmission Gonorrhoea and chlamydia screening for asymptomatic people with HIV and HIV PrEP users: open issues Host: Dr Fabiola Martin, Sexual Health Specialist and Associate Professor, Australian National University, Canberra, Australia Dr Thibaut Vanbaelen, physician and post-doctoral researcher at The Institute of Tropical Medicine in Antwerp, Belgium Dr Angelo Roberto Raccagni, physician at Vita-Salute San Raffaele University in Milan, Italy
Dr. Johan Melendez, a Johns Hopkins School of Medicine Assistant Professor, discusses STI antimicrobial resistance (AMR) and why Neisseria gonorrhoea is resistant, AMR diagnostic options such as point-of-care assays, and his work on evaluating AMR in resource-limited settings with National STD Curriculum Podcast Editor Dr. Meena Ramchandani. View episode transcript at www.std.uw.edu.This podcast is dedicated to an STD [sexually transmitted disease] review for health care professionals who are interested in remaining up-to-date on the diagnosis, management, and prevention of STDs. Editor and host Dr. Meena Ramchandani is an Assistant Professor of Medicine at the University of Washington (UW) and Program Director of the UW Infectious Diseases Fellowship Program.
A microbicide for Neisseria gonorrhoeae? In this episode Luis is joined by Dr. María Rendón from the University of Arizona. Dr. Rendón joins the podcast to talk about a novel microbicide that was developed which has activity against N. gonorrhoeae . How does it work? Does it affect commensal Neisseria? What about methylation signatures? Tune in to learn more about this microbicide.Link to articles referenced in episode:http://microbialcell.com/researcharticles/2019a-so-microbial-cell/https://www.cell.com/action/showPdf?pii=S1931-3128%2819%2930347-6Link to study: https://journals.asm.org/doi/abs/10.1128/aac.00794-24?doi=10.1128/aac.00794-24Questions? Feedback? Send those to letstalkmicro@outlook.comWant to support the podcast? Here's how:Venmo: https://venmo.com/u/letstalkmicroBuy me a Ko-fi: https://ko-fi.com/letstalkmicro
Meningitis B outbreaks: vaccination and risk in university settings
Send us a textOn this episode of the CMAJ Podcast, Dr. Blair Bigham and Dr. Mojola Omole explore the ongoing public health concern of meningococcal disease, focusing on meningitis B outbreaks in Canadian universities. They are joined by Dr. Cristin Muecke, a medical officer of health in Halifax, and Dr. Savita Rani, a public health specialist at the University of Saskatchewan. The episode also features the personal story of Megan Plamondon, a Queen's University student who contracted invasive meningococcal disease.The discussion opens with a look at recent meningitis B outbreaks, including cases at Dalhousie University in 2022 and Queen's University in 2023. The Halifax outbreak led to a targeted vaccination effort offering publicly funded MenB vaccines to students in congregate living environments, such as dormitories and residences.Dr. Muecke provides insights into the Halifax outbreak and the public health response that followed. She discusses the complexities of identifying and controlling meningococcal disease in university settings, where asymptomatic carriers of Neisseria meningitidis can unknowingly contribute to the spread of the infection.Dr. Rani expands on the current state of MenB vaccination, explaining why the vaccine is not included in routine immunization schedules and outlining the challenges of securing broader vaccine coverage across the country. She emphasizes the importance of early detection, given that meningitis can present with nonspecific symptoms which complicates diagnosis.Megan Plamondon's story brings a lived experience perspective to the conversation, highlighting the severe impact of meningococcal disease and the critical need for prevention efforts, particularly among students entering congregated living environments for the first time.Join us as we explore medical solutions that address the urgent need to change healthcare. Reach out to us about this or any episode you hear. Or tell us about something you'd like to hear on the leading Canadian medical podcast.You can find Blair and Mojola on X @BlairBigham and @DrmojolaomoleX (in English): @CMAJ X (en français): @JAMC FacebookInstagram: @CMAJ.ca The CMAJ Podcast is produced by PodCraft Productions
Ces dangereuses bactéries: la Neisseria meningitidis Si la majorité des bactéries sont inoffensives voire bénéfiques pour la santé, certains types de bactéries sont pathogènes et à l'origine de nombreuses maladies comme la peste, la tuberculose ou le choléra. Tout au long de la semaine, Anne Baecher propose de découvrir le monde complexe, fascinant et terrifiant de ces organismes microscopiques. Résistance aux antibiotiques, taux de mortalité élevé malgré les traitements. Jacques Schrenzel, chef du laboratoire de bactériologie et du laboratoire de génomique des Hôpitaux universitaires de Genève (HUG), fait le point sur la bactérie Neisseria meningitidis, responsable de la méningite. Micro sciences: le zèbre est-il blanc avec des rayures noires, ou lʹinverse? C'est une question qui m'a toujours amusée : le zèbre est-il blanc avec des rayures noires, ou noir avec des rayures blanches ? Figurez-vous que ce sont les mathématiques qui nous permettent de faire la lumière sur les motifs du zèbre (et sur ceux d'autres animaux). Michel Milinkovitch, professeur ordinaire au département de génétique et évolution de l'Université de Genève, m'explique comment ces motifs peuvent être expliqués par des formules mathématiques trouvées par deux pères fondateurs de l'informatique, Alan Turing et John von Neumann. La science en chansons: "Bébéboa" Stéphane Délétroz dévoile sa liste de chansons qui évoquent des concepts scientifiques et sʹamuse à les décortiquer. Dans cet épisode: "Bébéboa" (2021) dʹOrelsan pour parler dʹalcoolisme.
117. Meningococcal Vaccine: Prevention of Meningococcal Disease in Adolescents and Young Adults
On this episode of NP Pulse: The Voice of the Nurse Practitioner®, Drs. Mary Koslap-Petraco and Ruth Carrico will discuss meningococcal disease, the maze of meningococcal vaccines, ACIP recommendations and the use of shared clinical decision-making. Meningococcal disease — a life-threatening infection caused by Neisseria meningitidis — demands our attention. It strikes swiftly, leaving devastation in its wake. Still, we have powerful tools at our disposal: MenACWY and MenB vaccines, and a new, game-changing pentavalent vaccine that covers serogroups A, B, C, W and Y. Additionally, a meningitis point-of-care tool will be available on AANP's Tools and Resources page. To earn 1.0 contact hours of continuing education (CE) credit, you will need the participation code provided at the end of the podcast. To claim your CE credit, log in and register for the activity within the AANP CE Center, then enter the participation code and complete the post-test and evaluation. CE credit is available for this podcast through June 2025. This educational activity is supported by an independent medical education grant from GSK.
Episode 168: UTI in MalesFuture Dr. Tran gives a summary of UTIs in Males, including epididymitis, orchitis, urethritis, prostatitis, and pyelonephritis. Diagnosis and treatment were briefly described and some differences with female patients were mentioned by Dr. Arreaza. Written by Di Tran, MS-3, Ross University School of Medicine. Editing and comments by Hector Arreaza, MD.You are listening to Rio Bravo qWeek Podcast, your weekly dose of knowledge brought to you by the Rio Bravo Family Medicine Residency Program from Bakersfield, California, a UCLA-affiliated program sponsored by Clinica Sierra Vista, Let Us Be Your Healthcare Home. This podcast was created for educational purposes only. Visit your primary care provider for additional medical advice.WHAT ARE URINARY TRACT INFECTIONS?Urinary Tract Infection (UTI) is an infection of any part of the urinary tract system. It may involve any part of the renal system, the kidneys, the ureters, the bladder, the prostate, and the urethra. Different from men, a woman may get a UTI more easily due to their anatomical difference. A woman's urethra is shorter and lies close in proximity to both the vagina and the anus, which allows easy access for bacteria to travel up to the bladder.UTI is further subdivided into two different categories, depending on where the infection takes place within the urinary tract:Lower Tract Infection – cystitis and urethritis when the infection occurs on the bladder and the urethra, respectively. Common infections are a result of bacteria migrating from the skin (and also from sexual organs) to the urethra and ending up in the bladder.In males, other forms of lower tract infection can result in prostatitis, epididymitis, and orchitis.Upper Tract Infection - aka pyelonephritis, is a more concerning infection that involves the upper parts of the urinary system, in other words, the ureters, and kidneys.AGE DIFFERENCES IN UTI FOR MEN:For men, the incidence of UTI increases with age. Dr. John Brusch reports UTI rarely develops in young males and the prevalence of bacteriuria is 0.1% or less. Men who are 15-50 years of age often have urethritis due to sexually transmitted infection (STI), mainly by Neisseria gonorrhoeae and Chlamydia trachomatis. Symptoms include frequency, urgency, and dysuria (most common).Men who are 50 years or older, especially those with prostatic hyperplasia, will have signs and symptoms of incomplete bladder emptying, hesitancy, slow stream, difficulty initiating urination, and dribbling after urinating. Due to the enlargement of the prostate gland, there will be partial blockage of urine flow from the bladder, which in turn, creates a reservoir where bacteria can grow and cause an infection. The most common offending microorganism for this age group is Escherichia coli.Interestingly, while UTIs are rare among men under 60, by the age of 80, both women and men have similar incidence rates. The bladder tends to have a higher residual volume in older males because the prostate grows no matter what, it´s just a part of aging for males. Some may end up with more or less lower urinary tract symptoms, but the prostate is enlarged in general.Other risk factors for UTI in males are men who are not circumcised, urethral strictures, fistulas, hydronephrosis (or dilated ureters overfilled with urine due to failure of drainage to the bladder), and the use of urinary catheters. DIFFERENT TYPES OF UTIs IN MALES:EPIDIDYMITIS:The infection starts from the retrograde ascending route from the prostatic urethra, backing up to the vas deferens, and eventually ending in the epididymis.In men who are younger than 35 years of age, the usual pathogens are C. trachomatis and N. gonorrhoeae (sexually transmitted).In men who are older than 35 years of age, the usual offending agents are Enterobacteriaceae and gram-positive cocci (E. coli as mentioned previously).ORCHITIS:This unique UTI is caused by viral pathogens, such as mumps, coxsackie B, Epstein-Barr (EBV), and varicella (VZV) viruses. Several studies have shown that patients having orchitis have a history of epididymitis. Fortunately, this infection is uncommon, and it was the main reason to develop the MMR vaccine. It is caused by viruses other than mumps, so you can still have orchitis even if you are vaccinated. Antibiotics are not prescribed for viral orchitis.BACTERIAL CYSTITIS:Having a similar pathophysiology of ascending infection mechanism, male patients in this category often present frequency, urgency, dysuria, nocturia, and suprapubic pain. On a side note, having hematuria is concerning, especially without symptoms, because it's automatically a red flag that should prompt an immediate evaluation in search of other causes besides infection, such as underlying malignancy. Possible etiologies are calculi, glomerulonephritis, and even schistosomiasis infection that can ultimately result in squamous cell carcinoma of the bladder. Arreaza: Let me share a little anecdote about hematuria. One Sunday when I was a resident I woke up with hematuria. Of course, I immediately went to urgent care, knowing hematuria means trouble in men. I had a urine dipstick test, which was normal. The first thing the nurse practitioner asked me was, “Did you eat any beets?”, and I never eat beets, but that day I had a full bag of beet chips. So, yes, that was the cause of my pseudo-hematuria. Lesson learned: Always ask about beets when you have a patient with painless hematuria with a normal dipstick. PROSTATITIS:This is an infection of the prostate gland. The most common offending agent is E. coli. Acute prostatitis will present with signs of “acute” infection, such as fever, chills, and suprapubic pain. On rectal exam, we will find a prostate that is warm, swollen, boggy, and very tender. Make sure you perform a gentle prostate exam as you may spread bacteria to the blood and cause bacteremia and potentially sepsis. Patients are normally very sick and it is not your typical cystitis, but it is more severe. Chronic Prostatitis can arise from different causes, ranging from retrograde ascending infection, “chronic” exposure to urinary pathogens, and even autoimmune etiologies. The majority of patients often are asymptomatic. URETHRITIS:This infection is further classified into two groups, gonococcal and non-gonococcal. For gonococcal urethritis, N. gonorrhoeae is the most common pathogen. Agents of non-gonococcal urethritis include C. trachomatis, Ureaplasma, trichomonas, and Herpes Simplex Virus (HSV). Patients often present symptoms of dysuria, pruritus, and purulent penile discharge.PYELONEPHRITIS:Following a retrograde ascending mechanism, an infection may travel from the bladder and make its way to the kidney, causing damage and inflammation to the renal parenchyma. According to Dr. John Brusch, E. coli is responsible for approximately 25% of cases in males. Pyelonephritis presents with chills, fever, nausea/vomiting, flank pain/costovertebral angle tenderness, and dysuria. Other findings include pyuria and bacteriuria. Pyelonephritis is a common cause of sepsis. Diagnosis of UTIs.URINE STUDIES: Urine culture remains the gold standard for diagnosis of UTI. Other studies include suprapubic aspiration, catheterization, midstream clean catch, and Gram stain. Imaging studies are not always needed, but you may order plain films, ultrasonography, CT scans, and MRIs. It will depend on the severity of your case and your clinical judgment.UTIs in women: In males, we should perform urine culture and susceptibility studies. However, in women, urine studies are not needed all the time, they should be reserved for women with recurrent infection, treatment failure, history of resistant isolates, or atypical presentation. This is done to confirm the diagnosis and guide antibiotic selection.Interestingly, in a recent evidence review, published in the American Family Physician journal, women can self-diagnose their uncomplicated cystitis. All that is needed is having typical symptoms (frequency, urgency, dysuria/burning sensation, nocturia, suprapubic pain), without vaginal discharge. If you have those elements, you have enough information to diagnose, or even the patient can self-diagnose, an uncomplicated UTI without further testing, but in males, you should ALWAYS perform urine studies.TREATMENTS:Men with UTI should ALWAYS receive antibiotics, with urine culture and susceptibility results guiding the antibiotic choice. Laboratory results will help us determine the best treatment plan. UTIs are often treated with a variety of antibiotics. Dr. Robert Shmerling, of Harvard Medical School, states that most uncomplicated lower tract infections can be eradicated with a week of treatment with antibiotics. Common antibiotics for UTI are fluoroquinolones, trimethoprim-sulfamethoxazole (TMP-SMZ), minocycline, or nitrofurantoin.On another hand, if it's an upper tract infection or prostatitis, the course of treatment can be extended for longer periods. For those patients who are hemodynamically unstable or have severe upper UTI, hospital admission is required to monitor for complications and IV antibiotics.UTIs in males are less frequent than UTIs in females, except when patients are 80 years and older when the incidence is similar in both sexes. UTIs in males must prompt further evaluation because if left untreated, they can have detrimental effects on your patients' health. As a take-home point, UTI in males is less common than in females, and it requires urine studies or other studies to identify the etiology and guide treatment. Antibiotics are always used, and you may guide your treatment depending on the results. Imaging is not always needed, but use your clinical judgment to make a more specific diagnosis and detect complications promptly. __________Conclusion: Now we conclude episode number 168, “UTI is Males.” Future Dr. Tran described the different anatomical areas that can be infected in males with UTI. She reminded us that UTIs in males always need to be treated with antibiotics and urine cultures are done to guide treatment. Dr. Arreaza mentioned a few differences in the diagnosis and treatment of UTIs in females. For example, women can self-diagnose an uncomplicated cystitis, and urine studies or antibiotics are not always needed in women. This week we thank Hector Arreaza and Di Tran. Audio editing by Adrianne Silva.Even without trying, every night you go to bed a little wiser. Thanks for listening to Rio Bravo qWeek Podcast. We want to hear from you, send us an email at RioBravoqWeek@clinicasierravista.org, or visit our website riobravofmrp.org/qweek. See you next week! _____________________References:Shmerling, R. H. (2022, December 5). Urinary tract infection in men. Harvard Health Publishing. https://www.health.harvard.edu/a_to_z/urinary-tract-infection-in-men-a-to-z.Brusch, J. L. (2023a, March 27). Urinary tract infection (UTI) in males. emedicine.medscpae.com. https://emedicine.medscape.com/article/231574-overview.Kurotschka PK, Gágyor I, Ebell MH. Acute Uncomplicated UTIs in Adults: Rapid Evidence Review. Am Fam Physician. 2024;109(2):167-174. https://www.aafp.org/pubs/afp/issues/2024/0200/acute-uncomplicated-utis-adults.htmlRoyalty-free music used for this episode: Tropicality by Gushito, downloaded on July 20, 2023, from https://www.videvo.net/royalty-free-music/
Revisiting gonorrhoea: Update on the 4CMenB vaccine for gonorrhoea prevention
You will recall a previous podcast about preventing Neisseria gonorrhoea through an effective vaccine. Neisseria gonorrhoeae is a ubiquitous sexually transmitted bacteria that can cause both localised and systemic disease if left untreated. It may be transmitted to neonates. We also reported on a rise of the gonorrhoea incidence, as well as increasing rates of antibiotic resistance. Today we will revisit the implementation of vaccinations against gonorrhoea in the UK. Here is an exciting up-date on the advice provided by UK's Joint Committee on Vaccination and Immunisation, JCVI, on using the vaccine 4CMebB OMV against Meningococcus used off-label for the prevention of gonorrhoea infection • in patients at significant risk of infection with bacterial STIs who • attend specialist sexual health services. Host: Dr. Fabiola Martin, Sexual Health HIV, HTLV Specialist, Canberra Sexual Health Services & University of Queensland, Australia Participants: Dr. Suneeta Soni, Consultant in Sexual Health and HIV, University Hospitals Sussex and Chair of the Bacterial special interest group for BASHH *British Association for Sexual health and HIV) Dr. Yen Bui, Consultant in Vaccination and Travel Health, Institut national de santé publique du Québec, Canada A/P. Dr. Kate Seib, NHMRC Leadership Fellow and Associate Director for Research, Institute for Glycomics, Griffith University, Australia
Can Gonorrhea, Chlamydia, or Mgen Spontaneously Clear?
This episode reviews five articles regarding spontaneous clearance of Neisseria gonorrhoea, Chlamydia trachomatis, and Mycoplasma genitalium without the use of antibiotics. View episode transcript and references at www.std.uw.edu.This podcast is dedicated to an STD [sexually transmitted disease] review for health care professionals who are interested in remaining up-to-date on the diagnosis, management, and prevention of STDs. Editor and host Dr. Meena Ramchandani is an Assistant Professor of Medicine at the University of Washington (UW) and Program Director of the UW Infectious Diseases Fellowship Program.
Antimicrobial Resistance in Neisseria Gonorrhoeae (JCM ed.)
Gonorrhea remains one of the more common sexually transmitted infections. In North America, the number of reported cases has generally risen for over ten years, with interruptions in the early days of the COVID-19 pandemic, followed by returns to rising rates of infection. Under the selective pressure of antimicrobial treatment, antimicrobial resistance has risen, which has led to limited options for treatment Today, we will be discussing antimicrobial resistance in N. gonorrhoeae, including these questions: • How accurate is gradient diffusion susceptibility testing when compared to agar-dilution results? • Should we use analysis of whole genome sequencing results or agar dilution phenotypic results as the gold-standard for antibiotic susceptibility testing of N. gonorrhoeae? • What is the utility of beta-lactamase testing for predicting penicillin susceptibility results in N. gonorrhoeae? Guests: Dr. Tanis Dingle, Clinical Microbiologist at Alberta Precision Laboratories and a Clinical Associate Professor in the Department of Pathology and Laboratory Medicine at the University of Calgary. Dr. Angela Ma., Clinical Microbiologist at Public Health Ontario. Link: Use of genome sequencing to resolve differences in gradient diffusion and agar dilution antimicrobial susceptibility testing performance of Neisseria gonorrhoeae isolates in Alberta, Canada This episode of Editors in Conversation is brought to you by the Journal of Clinical Microbiology and hosted by JCM Editor in Chief, Alex McAdam and Dr. Elli Theel. JCM is available at https://jcm.asm.org and on https://twitter.com/JClinMicro. Visit journals.asm.org/journal/jcm to read articles and/or submit a manuscript. Follow JCM on Twitter via @JClinMicro
A statewide outbreak of meningococcal disease has infected 27 people since June 2022 and killed five of them, and Virginia Department of Health officials have declared a statewide outbreak of the disease. The illness is caused by the bacteria called Neisseria meningitidis type Y. The cases have been reported in eastern, central, and southwest Virginia during the past 15 months – about three times the expected number of cases during the same timeframe, according to VDH officials. Most cases are residents of eastern Virginia, where a regional outbreak was first announced in September 2022. The most recent notice to the...Article LinkSupport the show
Neisseria gonorrhoeae, in short NG, is a ubiquitous sexually transmitted bacteria that can cause both localised and systemic disease if left untreated. NG may also be transmitted vertically from mother to baby. Over the last years, we have seen a rise in the number of people diagnosed with gonorrhoea, alongside growing rates of antibiotic resistance. New research makes us hopeful that a vaccine may soon become available to provide global, large scale benefits. In this podcast, we explore this possibility with three experts in the field: Prof Kate Seib (1), Dr Claire Dewsnap (2) and Dr Silvia Nozza (3). Would you like to know more about the topic? Please read the paper we recently published in STI: "Prior Neisseria meningitidis (Nm) proctitis does not prevent Neisseria gonorrhoeae (Ng) proctitis among men who have sex with men (MSM)": https://sti.bmj.com/content/99/3/215 (1) NHMRC Leadership Fellow and Associate Director for Research, Institute for Glycomics, Griffith University, Gold Coast, Australia (2) President of the British HIV Association for HIV & Sexual Health (BASHH) and Consultant in Genitourinary Medicine, Sheffield Teaching Hospital, Sheffield, UK (3) Consultant in Infectious Diseases, Head of Prevention Unit, San Raffaele Hospital (IRCCS), Milan, Italy
Swabs vs. Urine | More Mental Health | Siblings of Abuse | Infants and COVID | Scan Too Much
The JournalFeed podcast for the week of June 12-16, 2023.These are summaries from just 2 of the 5 article we cover every week! For access to more, please visit JournalFeed.org for details about becoming a member.Swabs vs. Urine Spoon FeedVaginal swabs are more accurate than urine samples in diagnosing Chlamydia trachomatis, Neisseria gonorrhoeae, and Trichomonas vaginalis. These results support CDC recommendations that vaginal swabs are the preferred sample modality when testing for STIs in women.Infants and COVID Spoon FeedInfants who tested positive for SARS-CoV-2 were less likely to have UTI, bacteremia, and bacterial meningitis.
This episode reviews three articles about four antimicrobial treatment options for Neisseria gonorrhoeae other than ceftriaxone. View episode transcript and references at www.std.uw.edu.This podcast is dedicated to an STD [sexually transmitted disease] review for health care professionals who are interested in remaining up-to-date on the diagnosis, management, and prevention of STDs. Editor and host Dr. Meena Ramchandani is an Assistant Professor of Medicine at the University of Washington (UW) and Medical Director of the Public Health – Seattle & King County Sexual Health Clinic.
In this episode, we review the high-yield topic of Neisseria gonorrhoeae from the Microbiology section. Follow Medbullets on social media: Facebook: www.facebook.com/medbullets Instagram: www.instagram.com/medbulletsofficial Twitter: www.twitter.com/medbullets --- Send in a voice message: https://podcasters.spotify.com/pod/show/medbulletsstep1/message
Antimicrobial Resistance in Neisseria gonorrhoeae (AAC ed.)
The Center of Diseases Control and Prevention (CDC) has categorized emergent resistance in Neisseria gonorrhoeae as an “urgent” public health problem. We discuss the emerging problem of gonorrhea and implications for public health with experts in the field Topics discussed: The clinical implications of resistance to B-lactams and quinolones in Neisseria gonorrhoeae Mechanisms of resistance in these organisms Insights into therapeutic approaches to treat resistant gonococcal infections. Guests: William M. Shafer, Professor, Department of Microbiology and Immunology, Emory University School of Medicine, Co-Director, Emory Antibiotic Resistance Center Yonatan Grad, Melvin J. and Geraldine L. Glimcher Associate Professor of Immunology and Infectious Diseases, Harvard T. H. Chan School of Public Health This episode is brought to you by the Antimicrobial Agents and Chemotherapy journal available at aac.asm.org. If you plan to publish in AAC, ASM Members get up to 50% off publishing fees. Visit asm.org/membership to sign up. Visit journals.asm.org/journal/aac to browse issues and/or submit a manuscript.
3.27 Chlamydia Species Microbiology review for the USMLE Step 1 exam Chlamydia is a gram-negative bacteria that is an obligate intracellular organism. It has a two-part life cycle involving the reticular body (active form) and elementary body (inactive form). There are three main species of chlamydia that cause human infections: chlamydia trachomatis, chlamydia pneumoniae, and chlamydia psittaci. Chlamydia trachomatis is the most common sexually transmitted infection in the US and causes genital tract infections, lymphogranuloma venereum, pelvic inflammatory disease, and reactive arthritis. Treatment for chlamydia trachomatis includes azithromycin or doxycycline, and ceftriaxone is often added to cover Neisseria gonorrhoeae. Chlamydia trachomatis can also infect neonates during delivery, causing conjunctivitis and pneumonia. Chlamydia pneumoniae causes community-acquired pneumonia spread through respiratory droplets. Chlamydia psittaci is associated with pet birds and also causes pneumonia.
2022 STD Prevention Conference: Testing for Gonorrhea & Antimicrobial Resistance
This episode reviews four abstracts from the 2022 STD Prevention Conference Oral Session 1: Molecular Detection of Neisseria gonorrhoeae Antimicrobial Resistance and STI Strain Characterization. September 19, 2022. View episode transcript and download the Sexually Transmitted Diseases October 2022 issue at www.std.uw.edu.This podcast is dedicated to an STD [sexually transmitted disease] review for health care professionals who are interested in remaining up-to-date on the diagnosis, management, and prevention of STDs. Editor and host Dr. Meena Ramchandani is an Assistant Professor of Medicine at the University of Washington (UW) and Medical Director of the Public Health – Seattle & King County Sexual Health Clinic.
On episode #21 of the Infectious Disease Puscast, Daniel and Sara review the infectious disease literature for the previous two weeks, 1/18/23 – 2/1/23. Hosts: Daniel Griffin and Sara Dong Subscribe (free): Apple Podcasts, Google Podcasts, RSS, email Become a patron of Puscast! Links for this episode The impact of cold temperature in the pattern of influenza virus infection (OFID) Janssen to discontinue Phase 3 Mosaico HIV vaccine clinical trial (JNJ) Randomized trial of vaccines for Zaire Ebola virus disease (NEJM) PD-1 blockade and lenalidomide combination therapy for Epstein-Barr virus infection (CMI) Outcomes of Daptomycin plus Ceftaroline vs alternative therapy for persistent MRSA bacteremia (IJAA) Detection of a novel strain of multidrug-non-susceptible Neisseria gonorrhoeae (The Lancet) Impact of a device to reduce blood culture contamination and false-positive central-line bloodstream infections (ICHE) Addition of anaerobic coverage for treatment of biliary tract infections (JAC) High dose Cefepime vs Carbapenems for bacteremia caused by Enterobacterales(OFID) Assessing the diagnostic performance of IGRAs for Mycobacterium tuberculosis (CID) Infective endocarditis after transcatheter aortic valve replacement (JACC) Discordant clinical and microbiological outcomes are associated with late clinical relapse in clinical trials for complicated UTIs (CID) Real-world use of bezlotoxumab and fecal microbiota transplantation for the treatment of Cdiff (OFID) Blastomycosis in New England (OFID) Management of invasive candidiasis in hematopoietic cell transplant recipients (TCT) Short course of Antifungal therapy in patients with uncomplicated Candida Bloodstream infection (OFID) Parasites and childhood stunting (Cell) Comparing complication rates of midline catheter vs. PICC line (OFID) Novel prion strain as the cause of chronic wasting disease in a moose (EID) Agreement of respiratory viruses' detection between nasopharyngeal swab and bronchoalveolar lavage in adults with pneumonia (CMI) Music is by Ronald Jenkees
3.12 Neisseria Species Microbiology review for the USMLE Step 1 exam Neisseria species are gram negative diplococci that infect and live inside neutrophils Two main species that cause infections in humans: Neisseria gonorrhoeae and Neisseria meningitidis Neisseria gonorrhoeae causes the sexually transmitted infection gonorrhea, which is the second most common STI Risk factor for gonorrhea is unprotected sex with an infected person N. gonorrhoeae uses pilli to adhere to epithelial cells and invade, causing a local skin infection at the site of inoculation Females: cervix is the most common site of infection, causes cervicitis, symptoms include thick yellow or green vaginal discharge, dysuria, and pelvic pain. If left untreated, it can cause PID, ectopic pregnancy, infertility, and chronic pelvic pain Males: urethra is the most common site of infection, symptoms include yellow-green discharge, dysuria, and painful swollen testes (less common) If left untreated, it can infect more proximal structures and cause prostatitis Diagnosis is done by swabbing the urethra or cervix and sending it for nucleic acid amplification testing Can also cause septic arthritis (in contrast, Chlamydia causes reactive arthritis) "Gonorrhea gon go to the joints" Treatment typically involves a cephalosporin (like ceftriaxone) and azithromycin to also cover chlamydial infection Conjunctival gonorrhea can occur in newborns during the birthing process, causing conjunctivitis in the eye.
Dr. John Toney, Professor of Medicine at the USF Morsani College of Medicine, presents this STI treatment refresher updated for 2022-2023. Dr. Toney begins by reviewing the new changes to the latest 2021 STI guidelines (updated from 2015). He next discusses Chlamydia and Neisseria, Chancroid and LGV. Next, he discusses syphilis. Topics discussed related to syphilis includes differentiating primary, secondary, and latent disease, diagnostic testing and treatment. Dr. Toney closes by discussing genital Herpes and Trichomoniasis.
3.04 Gram Negative Bacteria Microbiology review for the USMLE Step 1 Exam. Gram negative bacteria are characterized by a thin cell wall surrounded by a lipid outer membrane They do not retain the violet gram stain and appear pink after staining Gram negative bacteria can be classified by shape: cocci, coccobacilli, bacilli, and spirals Gram negative cocci include Neisseria species, which can be further categorized as maltose fermenters or non maltose fermenters Gram negative coccobacilli include: Bordetella pertussis, Haemophilus influenzae, Pasteurella, Francisella tularensis, Brucella, and Acinetobacter Gram negative bacilli can be divided into lactose fermenting and non lactose fermenting categories Lactose fermenting gram negative bacilli include: Escherichia coli, Klebsiella, Enterobacter, Citrobacter, and Serratia Non lactose fermenting gram negative bacilli can be further divided into oxidase positive and oxidase negative Oxidase positive non lactose fermenting gram negative bacilli include Pseudomonas Oxidase negative non lactose fermenting gram negative bacilli include Shigella, Yersinia, and Salmonella Gram negative spirals can be divided into oxidase positive and oxidase negative categories Oxidase positive gram negative spirals include Vibrio species, Helicobacter pylori, and Campylobacter jejuni Oxidase negative gram negative spirals include Borrelia burgdorferi (cause of lyme disease) and Treponema pallidum (cause of syphilis)
The Best Clinical Microbiology Papers of 2022 (JCM Ed.)
As we enter into the holiday season, many of us look forward to celebrating long-standing traditions with family and friends, which is no different from us here on the podcast! While not necessarily as long-standing as some of the other classic holiday traditions, after 2.5 years on air, we on this podcast have established our own end-of-year tradition, which is to take a look back at some of our favorite papers or more intriguing manuscripts published in the Journal of Clinical Microbiology over the past year. And so as you'll see, thanks to the different areas of expertise and general interest among our panel today, we've selected quite a variety of papers to discuss, ranging from evaluation of new blood culture systems to use of metagenomics for infective endocarditis and to the potential application of interferon gamma release assays for detection of Histoplasma infections. And so, suffice it to say, there will be something of interest for everyone listening. But, for those watching today, you are clearly getting an extra special treat as you get to see us do this episode wearing our best holiday gear and accessories. Guest: Dr. Trish Simner. Links: Nasal Swab Performance by Collection Timing, Procedure, and Method of Transport for Patients with SARS-CoV-2. DOI: https://doi.org/10.1128/JCM.00569-21 Multicenter Postimplementation Assessment of the Positive Predictive Value of SARS-CoV-2 Antigen-Based Point-of-Care Tests Used for Screening of Asymptomatic Continuing Care Staff. DOI: https://doi.org/10.1128/JCM.01411-21 Laboratory Safety: Handling Burkholderia pseudomallei Isolates without a Biosafety Cabinet. DOI: https://doi.org/10.1128/JCM.00424-21 The clinical utility of 2 high-throughput 16S rRNA gene sequencing workflows for taxonomic assignment of unidentifiable bacterial pathogens in MALDI-TOF MS. DOI: https://doi.org/10.1128/JCM.01769-21 Performance of Fully Automated Antimicrobial Disk Diffusion Susceptibility Testing Using Copan WASP Colibri Coupled to the Radian In-Line Carousel and Expert System. DOI: 10.1128/JCM.00777-21 Benefits Derived from Full Laboratory Automation in Microbiology: A Tale of Four Laboratories. DOI https://doi.org/10.1128/JCM.01969-20 Reflex Detection of Ciprofloxacin Resistance in Neisseria gonorrhoeae by Use of the SpeeDx ResistancePlus GC Assay. DOI: https://doi.org/10.1128/JCM.00089-21 Comparative Performance of Latest-Generation and FDA-Cleared Serology Tests for the Diagnosis of Chagas Disease. DOI: https://doi.org/10.1128/JCM.00158-21 Diagnosing Pulmonary Tuberculosis by Using Sequence-Specific Purification of Urine Cell-Free DNA. DOI: https://doi.org/10.1128/JCM.00074-21 Indeterminate QuantiFERON Gold Plus Results Reveal Deficient Interferon Gamma Responses in Severely Ill COVID-19 Patients. DOI: https://doi.org/10.1128/JCM.00811-21 Visit journals.asm.org/journal/jcm to read articles and/or submit a manuscript. Follow JCM on Twitter via @JClinMicro
Educational Pearls: Most common sexually transmitted disease (STD) in North America: Human Papillomavirus (HPV) From the emergency department patients should be connected to follow-up care and educated on vaccine series Most common non-viral STD in North America: Trichomonas Vaginalis While men may be asymptomatic, they can transmit the disease to women who may experience irritation leading to increased likelihood of PID and contraction of other STDs and HIV Trichomonas is diagnosed via wet preparation with visualization of motile parasites Similarly, men's urine can be tested for visualized motile parasites Expedite lab as parasites are motile for about one hour PCR test is becoming more available Most common bacterial STD in North America: Chlamydia trachomatis Neisseria gonorrhoeae is a less common bacterial STD but does have high rates of drug resistance Empiric STD treatment includes IM Ceftriaxone and PO Doxycycline Providers should consider adding Flagyl for Trichomonas Vaginalis coverage ReferencesSexually transmitted disease surveillance, 2020. Centers for Disease Control and Prevention. https://www.cdc.gov/std/statistics/2020/default.htm. Published August 22, 2022. Accessed November 21, 2022. Workowski KA, Bachmann LH, Chan PA, et al. Sexually Transmitted Infections Treatment Guidelines, 2021. MMWR Recomm Rep. 2021;70(4):1-187. Published 2021 Jul 23. doi:10.15585/mmwr.rr7004a1 Summarized by Kirsten Hughes, MS4 | Edited by John Spartz, MD, & Erik Verzemnieks, MD In an effort to promote diversity, equity, and inclusion in Emergency Medicine, The Emergency Medical Minute is proud to present our 2nd annual Diversity and Inclusion Award. We support increasing the representation of underrepresented groups in medicine and extend this award to individuals applying to emergency medicine residencies during the 2022-2023 cycle. For information on award eligibility and the application process, visit https://emergencymedicalminute.com/edi-award/ Donate to EMM today!
Dr. Carole Keim MD takes listeners through vaccines in today's episode. She explains everything from how vaccines are created to common myths and misconceptions about them. She then details each baby and childhood vaccine, and what disease each prevents.Dr. Keim breaks down how vaccines work and what criteria they must meet in disease to be effective. She explains the four main types of vaccines and lays each vaccination out in a clear manner, covering what age your baby or child will be when they receive the vaccine and how the immune response works. These vaccines are proven to protect your baby against everything from tetanus to mumps to pertussis and more.This episode will cover: How vaccines workCriteria to create a vaccineThe 4 different types of vaccinesCommon myths or misconceptions about vaccinesSpecific vaccines (all routine childhood vaccines)Total number of vaccinesCommon side effects and red flags, how to treat How vaccines work: 00:44The purpose of vaccines is to trigger an immune response faster and with less harm than the original disease.The immune system is a lot like a microscopic team of superheroes, made up of white blood cells, antibodies, the complement system, and a few others. These superheroes fight villains such as bacteria, viruses, and other pathogens. If they cannot fight them fast enough, the villains will multiply and cause symptoms of disease. Vaccines give your superhero team information about what the villains look like, so they can recognize them as soon as they enter the body, and fight them off quicker and easier.Vaccine criteria: 01:26In order to make a vaccine, certain conditions must be metIt has to be effective. We must be able to become immune to the pathogen; diseases like RSV and HFM are ones we can catch multiple times. Chickenpox is one that you become immune to after catching it once.The pathogen must not be able to mutate faster than the vaccine can be given - we do flu boosters annually because the flu virus mutates about that often. HIV and common cold mutate too fast for a vaccine to be developed.The vaccine must be cost-effective; it has to be cheaper to prevent the disease than to treat itThere are 4 main types of vaccines: 02:31Inactivated (killed pathogens)Live attenuated (weakened pathogens)Toxoid (a piece of what's inside the pathogen)mRNA vaccines Inactivated vaccines 03:44Most common typeThe bacteria or viruses in the vaccine are killed, so your immune system can safely learn to recognize the pathogen that it is trying to fight off. These vaccines do not have the potential to cause actual disease. What they do is cause the immune system superheroes to practice fighting the villains, kind of like practicing on dummies, which may cause mild signs of illness - fever, sore muscles, crankiness, or other symptoms. Examples: IPV (polio), HPV (human papillomavirus), HiB (Haemophilus influenzae B), pneumococcus (Streptococcus pneumoniae), meningococcus (Neisseria meningitidis), and Hepatitis A and B vaccines.Live attenuated vaccines 04:02Made from bacteria or viruses that have been exposed to chemicals that make them weaker than the natural or “wild type” bacteria or virus. Since these pathogens are not killed completely, your superheroes aren't just practicing on dummies, they are actually fighting the weakened villains. So it is possible to have symptoms of the disease, but milder. Some people with weakened immune systems may not be able to fight them off, and can get the actual disease. People taking steroid medications or immune suppressants, or who have HIV or other immune deficiencies should consult a doctor about whether it is safe to receive these vaccines. Examples: oral polio vaccine, MMR (measles, mumps, and rubella), Varicella zoster (chickenpox), and rotavirus vaccines.Toxoid vaccines 04:55Made from just part of the pathogen, and protect against the kinds of bacteria that cause symptoms after the toxins inside them are released. These toxin-carrying bacteria are like villains carrying around a bottle of poison, and the toxoid vaccine gives the superheroes the poison to sample and build up resistance to it. Example: DTaP (diphtheria, tetanus, and acellular pertussis).MRNA vaccines 05:23Newest typemRNA is like a copy of instructions. These give your immune system something like a sewing pattern to print out and make the dummies for your body to fightExample: some COVID vaccinesMyths and misconceptions about vaccines: 05:45Many parents have concerns about vaccinating their children. It only takes one serious reaction to call into question the safety of vaccines. And it has been so long since the vaccine-preventable diseases have run rampant that we in the United States don't fully understand the scope of what is being prevented. Here are some of the top concerns that I have heard from parents, and the truth behind them.Aluminum. There is aluminum in vaccines, but the amount is far less than babies get from other sources. The total amount of aluminum that babies get from vaccines in the first 6 months is 4.4mg. Breastfed babies consume 7mg, formula-fed babies consume 38mg, and babies on soy formula consume 114mg of aluminum in the first 6 months of life. Consuming aluminum vs. having it injected in a vaccine looks the same to the body, so the tiny amount of aluminum in vaccines will not harm your babyAntigens. An antigen is any microscopic substance that has the possibility to elicit an immune response. Babies are exposed to over a trillion antigens in the first year that naturally occur in the environment. The entire vaccine series that children receive today contains just over 150 antigens. A young baby's immune system can easily recognize these few antigens and make antibodies to the diseases without getting sick.Autism. It has been proven that vaccines do NOT cause autism. The age that children first start showing signs and can be tested for autism is 15-24 months. This is the same age that children receive booster vaccines, so it is understandable that some parents think they are related. Long-term protection. Vaccines will protect a person for just as long as if they got the original disease. So a person who had chickenpox as a child is just as protected from getting it again as a person who has received the chickenpox vaccine. Some people do not seroconvert (develop antibodies to that disease) - that depends on their immune system and is not a failure of the vaccine itself.Mercury. There used to be a preservative called thimerosal in vaccines. That preservative (which contains mercury) has been removed from all vaccines in the US that children receive. The only vaccine that still contains thimerosal is the adult flu vaccine.Unnatural exposure. Some people worry that getting exposed to a disease through an injection is not the same as getting it “naturally” by being exposed to a sick person. This is not true; any disease will get into your bloodstream, which is where it is recognized by the body, and once in there the body has no idea how it got in. So getting an injection looks exactly the same to your immune system as getting the disease from a sick person.Doctors DO NOT get paid to vaccinate childrenVaccines are NOT a punishment for children who are behaving badlySpecific vaccines: 10:47Hep B - 0, 2, 6 mos. Hepatitis B is a viral infection that can be passed from mom to baby through the placenta or during delivery. 90% of babies born with HepB will develop chronic infection and are at risk of liver cancer later in life.DTaP - 2, 4, 6, 15 mos, 4 years. Tdap - age 11, every 10 years. DTaP has more diphtheria, Tdap has more tetanus. Bacterial infections. Diphtheria causes severe sore throat and enlarged tonsils, and can block the airway from swelling/tonsils being so enlarged. Tetanus makes spores that live in soil; any penetrating wound could have tetanus in it (nail/thumbtack, dog or cat bite) and tetanus is not killed by antibiotics so it must be prevented. Pertussis is whooping cough and causes babies less than a year old to stop breathing. Everyone who takes care of the baby should be current on their TDaP (within 10 years). Polio - 2, 4, 6 mos, 4 years. Polio is a virus that attacks nerves and causes paralysis. Sometimes it's minor, and sometimes it's the diaphragm that's affected and they stop breathing. There is no specific treatment for polio.HiB - 2, 4, 6, 12-18 mos. HiB (haemophilus influenzae B) bacterial infection that affects children less than 5 years, and especially those under 1 year of age. It used to cause severe infections like epiglottitis, sepsis, pneumonia, and meningitis. PCV - 2, 4, 6, 12-18 mos. PCV = pneumococcal conjugate vaccine, pneumococcus is another name for streptococcus pneumonia, which is a kind of strep that gets into the bloodstream and causes sepsis, pneumonia, and meningitis. PCV has 13 strains of strep in it right now.Rotavirus - 2, 4, 6 mos. Viral infection that causes severe diarrhea and dehydration in babies. Hep A - 12 and 18 mos. Hep A is a type of food poisoning, there's no specific treatment. MMR - 1 and 4 years. Measles causes high fever, rash, and can cause brain damage, hearing loss, and death. Mumps causes parotitis (infection of salivary glands), but in boys also causes orchitis (inflammation of testicles) and can lead to sterility. Rubella is a fever and rash; more dangerous to unborn babies, causes miscarriages and birth defects.VZV - 1 and 4 years. Varicella Zoster virus (chickenpox) causes cold symptoms, fever, and an itchy and painful rash in children, and shingles in adults. VZV in pregnancy causes miscarriages and birth defects.MCV - 11 and 16 years. Meningitis A, C, W, Y are viruses that cause inflammation around the brain that develops quickly and can be fatal. HPV - 11 years. Human papilloma virus causes warts and dysplasia and can lead to cancer of the mouth, throat, anus, cervix, and penis. Currently 9 strains of HPV in the vaccine. Flu: recommended annually COVID: recommendations are still evolvingVaccines that are available but not given routinely: MenB, PPSV23, Dengue, Typhoid, japanese encephalitis, yellow fever, rabiesTotal numbers of vaccines: 22:351 at birth (Hep B)2 mos: DTaP, polio, HiB, Hep B, PCV, rotavirus - 1 or 2 combo vaccines, PCV and rota = 2 or 3 shots plus an oral vaccine4 mos: DTaP, polio, HiB, PCV, rotavirus - 1 combo plus PCV and rota = 2 shots and one oral6 mos: DTaP, polio, HiB, Hep B, PCV, rotavirus - 1 or 2 combo vaccines, PCV and rota = 2 or 3 shots plus an oral vaccine6+ mos: flu vaccine annually12-18 mos: 2 doses Hep A, 1 of DTaP, HiB, PCV, MMR, VZV. 5-7 shots depending on combos.4-6 years: DTaP, polio, MMR, VZV, typically given as 2 combo vaccines11 years: Tdap, MCV, 2 doses HPV16 years: MCV21+ years: Tdap every 10 years; booster if you have a wound and it's been less than 5 years, booster while pregnant9 shots and 3 oral before 1 year of age, 5-7 shots from age 1-2, 2 shots age 4-6, 4 at age 11, 1 at age 16 = 21-23 total shots before adulthood. 18 flu shots. Common vaccine reactions: 23:53Birth: nothing; sometimes redness/swelling2-6 mos: redness and swelling (local reaction), can be as much as the entire thigh and still be considered normal. Low grade fevers.12-18 mos and 4-6 years: muscle soreness, MMR and VZV cause fevers, VZV sometimes causes rash, other vaccines can cause local reactions11yrs: muscle soreness, local reaction with Tdap and MCV, fainting with HPV16 yrs: local reaction from MCVTdap boosters: muscle sorenessFlu, COVID: flu-like symptomsIt is NOT normal to have a body rash or vomiting after vaccines; those are signs of allergyLarge local reactions and muscle soreness can be treated with cool compresses (wet washcloth) and/or acetaminophen or ibuprofen. Fever or flu-like symptoms: acetaminophen or ibuprofenI DON'T recommend pre-medicating your child before vaccinesIf your child has an adverse reaction to a vaccine, you should report it to VAERS (vaccine adverse event reporting system). Remember that VAERS is like Yelp for vaccines, so take that about as seriously as you would a Yelp review.All of this information is also in The Baby Manual book, which is available for purchase. Remember it is always okay to call your doctor or emergency services if you have concerns about your baby's health. Resources discussed in this episode:The Baby Manual - Available on AmazonVAERS--Dr. Carole Keim MD: linktree | tiktok | instagram
The Centers for Disease Control and Prevention just updated guidelines for sexually transmitted infections (previously sexually transmitted diseases) for everything by HIV. In this multi-part series, host Geoff Wall will break down what's new and what's changing in practice.The GameChangerA 7-day course of doxycycline in the treatment of urogenital chlamydia is preferred and has been shown to be more efficacious compared to azithromycin. Ceftriaxone should be the treatment of choice for gonorrhea as there have been no “resistance”-related treatment failures identified in the United States at any anatomical site. Show Segments00:00 – Introduction01:45 – STI Guidelines02:34 – Chlamydia 14:56 – Gonorrhea 28:57 – Closing RemarksHost Geoff Wall, PharmD., BCPS, FCCP, CGP Professor of Pharmacy Practice, Drake University Internal Medicine/Critical Care, UnityPoint Health All relevant financial relationships have been mitigated. References and Resources CDC Sexually Transmitted Infections Treatment Guidelines, 2021Redeem your CPE or CMECPE (Pharmacist)CME (Physicians) Get a membership & earn CE for GameChangers Podcast episodes (30 mins/episode)Pharmacists: Get a membershipPrescribers: Get a membership CE Information Learning Objectives Describe the treatment of Neisseria gonorrhea based on the 2021 recommendationsDiscuss pharmacotherapy options for patients with chlamydia with or without concomitant gonorrhea infections0.05 CEU/0.5 Hr UAN: 0107-0000-22-224-H01-P Initial release date: 06/062022 Expiration date: 06/06/2023 Additional CPE and CME details can be found here.
Episode 89: Gonorrhea Basics. Written by Robert BensacenezRobert, Dr. Schlaerth, and Dr. Arreaza discuss the basics of gonorrhea, including presentation, treatment, and even a potential gonococcal vaccine.Introduction: Gonorrhea is commonly known as “the clap” or “the drip”. This ancient disease, described as “the perilous infirmity of burning” in a book called The History of Prostitution, has been treated with many remedies throughout history, including mercury, sulfur, silver, multiple plants, and even gold. Today we will discuss the clinical features, diagnosis, and current therapy of gonorrhea. By the way, did you know that gonorrhea in Spanish is used as an insult in Colombia? Well, now you know it. Definition: Gonorrhea is a sexually transmitted disease caused by the bacterium Neisseria gonorrhoeae (common name gonococcus), which is a gram-negative, intracellular, aerobic, diplococci. This disease leads to genitourinary tract infections such as urethritis, cervicitis, pelvic inflammatory disease (PID), and epididymitis. This is Rio Bravo qWeek, your weekly dose of knowledge brought to you by the Rio Bravo Family Medicine Residency Program from Bakersfield, California. Our program is affiliated with UCLA, and it's sponsored by Clinica Sierra Vista, Let Us Be Your Healthcare Home. ___________________________Gonorrhea. Written by Robert Besancenez, MS4, Ross University School of Medicine. Moderated and edited by Hector Arreaza, MD. Discussion participation by Katherine Schlaerth, MD. Epidemiology: The disease primarily affects individuals between 15–24 years of age (half of the STI patients in the US). CDC estimates that approximately 1.6 million new gonococcal infections occurred in 2018. Incidence rates are highest among African Americans, American Indians, and Hispanic populations.Transmission is sexual (oral, genital, or anal) or perinatal (causing gonococcal conjunctivitis in neonates). Risk factors include unsafe sexual behaviors (lack of barrier protection, multiple partners, men who have sex with men (MSM), and asplenia, complement deficiencies. Individuals with low socioeconomic status are at the highest risk: poor access to medical treatment and screening, poor education, substance use, and sex work. Presentation: The incubation period is ~ 2–7 days, and sometimes patients do not develop any symptoms. Urogenital infection: Gonorrhea is commonly asymptomatic, especially in women, which increases the chance of further spreading and complications. When symptoms are present, typical symptoms include purulent vaginal or urethral discharge (purulent, yellow-green, possibly blood-tinged). Discharge is less common in female patients. Urinary symptoms include dysuria, urinary frequency, and urgency. Male: - Typical presentation is urethritis. - Penile shaft edema without other signs of inflammation.- Epididymitis: unilateral scrotal fullness sensation, scrotal swelling, redness, tenderness, relief of pain with elevation of scrotum —Prehn Sign— and positive cremasteric reflex.- Robert: Prostatitis: fever, chills, general malaise, pelvic or perineal pain, cloudy urine, prostate tenderness (examine prostate gently). Female: - Cervicitis: Friable cervix and discharge (purulent, yellow, malodorous), - PID: pelvic or lower abdominal pain, dyspareunia, fever, cervical discharge, cervical motion tenderness but also uterine or adnexal tenderness, abnormal intermenstrual bleeding. PID can be subclinical and diagnosed retroactively when tubal occlusion is discovered as part of a workup for infertility. PID can cause Fitz-Hugh-Curtis syndrome (perihepatitis with RUQ pain).- Bartholinitis presents with introitus pain, edema, and discharge from the labia. - Vulvovaginitis may occur but is rare (due to the tissue preference of gonococci)Extragenital infection: Proctitis: Rectal purulent discharge, possible anorectal bleeding and pain, rectal mucosa inflammation, or rectal abscess (less common).Pharyngitis: sore throat, pharyngeal exudate, cervical lymphadenitis. Disseminated gonococcal infection (DGI): Triad of arthritis, pustular skin lesions, and tenosynovitis. As mentioned in Episode 46, on December 23, 2020, the California Department of Public Health (CDPH) sent a “Dear Colleague” letter to warn the medical community about the increased cases of DGI in California and Michigan. Increased cases may be caused by decreased STD testing and treatment because of the COVID-19 pandemic, and not necessarily because of a more virulent strain of gonorrhea. Later, treatment of gonorrhea was updated because of resistance. Epidemiology: ∼ 2% of cases. Most common in individuals younger than 40 years old, the female to male ratio is 4:1. A history of recent symptomatic genital infection is uncommon. Asymptomatic infections increase the risk of dissemination due to delayed diagnosis and treatment. Clinical features: Two distinct clinical presentations are possible. Arthritis-dermatitis syndrome:Polyarthralgias: migratory, asymmetric arthritis that may become purulent.Tenosynovitis: simultaneous inflammation of several tendons (e.g. fingers, toes, wrist, ankle).Dermatitis: vesicular, pustular, or maculopapular lesions, possibly with a necrotic or hemorrhagic center. Most commonly distributed on the trunk, extremities (sometimes involving the palms and soles). Typically, < 10 lesions with a transient course (subside in 3–4 days). Additional manifestations: fever and chills (especially in the acute phase). Purulent gonococcal arthritis: Abrupt inflammation in up to 4 joints (commonly knees, ankles, and wrists). No skin manifestations, rarely tenosynovitis. Genitourinary manifestations in only 25% of affected individuals. Not to be confused with reactive arthritis. Health care providers living in California: Order Nucleic acid amplification test (NAAT) and culture specimens from urogenital, extragenital mucosal sites (e.g., pharyngeal and rectal), and from disseminated sites (e.g., skin, synovial fluid, blood, and cerebrospinal fluid) before initiating empiric antimicrobial treatment for patients with suspected DGI. Report within 24 hours of diagnosis to the California Department of Public Health. Complications of DGI: sepsis with endocarditis, meningitis, osteomyelitis, or pneumonia. Diagnosis of gonorrhea: The test of choice is Nucleic acid amplification testing (NAAT) of first-catch urine or swabs of urethra, endocervix and pharynx, and synovial fluid in disseminated infection. Other possible tests: gram stains and bacterial cultures (Thayer-Martin agar, useful for antibiotic resistance, results may take 48 hours, sensitivity is lower than NAAT.)Synovial fluid analysis: Appearance of fluid can be clear or cloudy (purulent), high Leukocyte count (up to 50,000 cells/mm3): especially segmented neutrophils, gram stain positive in < 25% of cases. Treatment: Ceftriaxone and doxycycline for uncomplicated cases, but may require different approaches in case of allergies or intolerance to these antibiotics, or in severe cases. Uncomplicated gonorrhea (affecting cervix, urethra, rectum, pharynx)First-line treatment: single-dose ceftriaxone 500 mg IM (1 G for patients >150 Kg) PLUS doxycycline 100 mg PO twice a day for 7 days If a chlamydial infection has not been excluded.During pregnancy: Ceftriaxone PLUS single-dose azithromycin 1 gram PO(doxy is contraindicated – teratogen) Complicated gonorrhea (salpingitis, adnexitis, PID/ epididymitis, orchitis)Single-dose ceftriaxone IM PLUS doxycycline PO for 10–14 days (women may require additional administration of Metronidazole PO for 14 days). DGICeftriaxone IV every 24 hours for 7 days In case Chlamydia infection has not been ruled out: PLUS doxycycline PO twice a day for 7 daysDrainage of purulent joint(s) Sequelae: Without treatment, a prolonged infection may lead to complications, such as hymenal and tubal synechiae that lead to infertility in women. Prevention:-Screening for gonorrhea (USPSTF recommendations, September 2021, Grade B): Annual NAAT screening of gonorrhea AND chlamydia for sexually active women ≤ 24 years (including pregnant persons) or > 25 years with risk factors (e.g. new or multiple sex partners, sex partner with an STI, etc.). Evaluate for other STIs if positive (e.g. chlamydia, syphilis, and HIV). There is insufficient evidence to recommend for or against screening gonorrhea in asymptomatic males (Grade I).In all patients: Evaluate and treat the patient's sexual partners from the past 60 days. Provide expedited partner therapy if the timely evaluation of sexual partners is not feasible. Single-dose cefixime PO (if chlamydia has been excluded in the patient) OR Single-dose cefixime PO PLUS doxycycline PO for 7 days. Sexual partners must be treated simultaneously to avoid reinfections. A possible gonococcal vaccine: A gonococcal vaccine is theoretically possible, let's remember that the meningococcal vaccine exists. Meningococcus is closely related to gonococcus. A study published in 2017 showed that MeNZB® (a vaccine used in New Zealand until 2011 to fight against a meningitis epidemic) provided partial protection against gonorrhea. Food for thought for you guys. Conclusion: Let's remember to screen asymptomatic women for gonorrhea, identify symptomatic patients and start treatment promptly, and prevent serious complications, and more importantly, let's promote safe sex practices to prevent this disease.Now we conclude our episode number 89 “Gonorrhea Basics”. Gonorrhea affects mainly the urogenital area, but it can spread to the pharynx, rectum, skin, and even joints. When you see septic arthritis in patients with high risk for gonorrhea, suspect disseminated gonococcal infection and start treatment promptly. Even without trying, every night you go to bed being a little wiser.Thanks for listening to Rio Bravo qWeek. If you have any feedback about this podcast, contact us by email at RioBravoqWeek@clinicasierravista.org, or visit our website riobravofmrp.org/qweek. This podcast was created for educational purposes only. Visit your primary care physician for additional medical advice. This week we thank Hector Arreaza, Robert Besancenez, and Katherine Schlaerth. Audio edition: Suraj Amrutia. See you next week! _____________________References:Seña, Arlene C, MD, MPH; and Myron S Cohen, MD. Treatment of uncomplicated Neisseria gonorrhoeae infections, UpToDate, updated on Jan 27, 2022. Accessed on April 5, 2022. https://www.uptodate.com/contents/treatment-of-uncomplicated-neisseria-gonorrhoeae-infections Ghanem, Khalil G, MD, PhD. Clinical manifestations and diagnosis of Neisseria gonorrhoeae infection in adults and adolescents, UpToDate, updated on Sep 17, 2021, accessed on April 5, 2022. https://www.uptodate.com/contents/clinical-manifestations-and-diagnosis-of-neisseria-gonorrhoeae-infection-in-adults-and-adolescents Klausner, Jeffrey D, MD, MPH. Disseminated gonococcal infection, UpToDate, updated on March 3, 2022. Accessed on April 5, 2022. https://www.uptodate.com/contents/disseminated-gonococcal-infection Petousis-Harris H, Paynter J, Morgan J, et al. Effectiveness of a group B OMV meningococcal vaccine on gonorrhea in New Zealand – a case control study. Abstract presented at: 20th International Pathogenic Neisseria Conference. Manchester, UK; 2016.
This episode features an interview with Dr. Charlene Kahler from the Marshall Centre for Infectious Diseases Research and Training at the University of Western Australia. She discusses and article titled "Neisseria species and their complicated relationships with human health". Tune in to this episode to find out more information about different species of Neisseria and their significance in the human body.Link to article: https://www.publish.csiro.au/ma/fulltext/ma21024
Episode 68 -- Meningitis and Encephalitis – An Interview with Dr. Andrew Hogan
Episode 68 -- Emergency Department Management of Adults With Infectious Meningitis and Encephalitis – An Interview with Dr. Andrew HoganEMplify -- April 2022Interview with the Author: Andrew N. Hogan, MD1.Meningitis vs encephalitisWhy this topic?What do the words mean? What's the difference?2.Bacterial meningitisHow common is it in the US? Is it more common in third world countries?Mortality rate in the USCauses – if Neisseria and H influenzae improved post vaccination, why not S pneumoniae disease ? (Table 1)3.Viral meningitisHow common is it in the US?What are the common causes? (Table 2)4.Viral encephalitisSame prognosis as viral meningitis?Same organisms as viral meningitis? (Table 2)Does COVID-19 cause this illness?5.Fungal infectionsWho gets these?60% die? 1 million cases a year, 600K deaths?6.Prehospital care:What does EMS need to know?How do they protect themselves from being exposed?How can they help us make the diagnosis?EMS is giving antibiotics in some areas?PEP7.ED evaluation: History8.ED evaluation: Physical exam9.Diagnostics: CSFWhat's large volume? Is it safe?Cell counts on tubes 1+4, all the time or only if traumatic and obviously bloody?Is opening pressure helpful?CSF lactate level – can this be run in a normal lactic acid analyzer?PCR/NAAT testing10.Serum labsWhat is helpful?Serum PCRSerum cryptococcal antigen11.Imaging Is CT imaging before LP still necessary? Can we be selective?Is MRI helpful in the ED, or is there a role in encephalitis?12.TreatmentAntibioticsSteroids: Who gets them? When? Are there downsides of giving them?13.Special populationsAutoimmune diseaseLacking childhood vaccinesHealthcare associated infections14.Cutting edge15.Disposition
Neisseria gonorrhoeae is the second most common bacterial sexually transmitted infection in the world, and it has become a superbug. It has developed resistance to every antibiotic currently approved for treatment, and multidrug-resistant strains have been identified globally. Hear from clinicians advocating for their patients, a global leader, and a leading expert in drug development on actions needed to combat resistant gonorrhea. Learn more about our guests this episode: Teodora Wi: https://www.who.int/campaigns/world-antimicrobial-awareness-week/2018/features-from-around-the-world/super-gonorrhoea-q-a-with-dr.-teodora-wi Matthew Hamill: https://www.hopkinsmedicine.org/profiles/details/matthew-hamill Yuka Manabe: https://www.hopkinsmedicine.org/profiles/details/yukari-manabe Edward Hook: https://apps.medicine.uab.edu/FacultyDirectory/FacultyData.asp?FID=7333 This podcast is co-created by CIDRAP-ASP and the Antimicrobial Resistance Fighter Coalition (ARFC). Theme music Artist: Derek Sandbeck Song Title: Power Plugs & Superbugs
In Season 2 of Superbugs and You, we continue to focus on the threat of antimicrobial resistance, which occurs when bacteria, viruses, fungi and parasites change over time and no longer respond to antibiotics and other medicines. In other words, they become “Superbugs”. This season, we will focus on Methicillin-resistant Staphylococcus aureus, Clostridioides difficile infections, resistant Neisseria gonorrhoeae, and the impact of antimicrobial resistance on modern medicine. Each episode will feature discussions with patients, physicians, and scientists to find out what's causing antimicrobial resistance, how it affects the lives of ordinary people, and most importantly, what we can do to stop it. Subscribe for new episodes beginning on October 20th! This podcast is co-created by the Center for Infectious Disease Research & Policy (CIDRAP) and the Antimicrobial Resistance Fighter Coalition. Visit the CIDRAP Antimicrobial Stewardship Project website: https://www.cidrap.umn.edu/asp Visit the Antimicrobial Resistance Fighter Coalition website: https://antimicrobialresistancefighters.org/ Theme music Artist: Derek Sandbeck Song Title: Power Plugs & Superbugs
SGEM#335: Sisters are Doin’ It for Themselves…Self-Obtained Vaginal Swabs for STIs
Date: June 25th, 2021 Guest Skeptic: Dr. Chris Bond is an emergency medicine physician and assistant Professor at the University of Calgary. He is also an avid FOAM supporter/producer through various online outlets including TheSGEM. Reference: Chinnock et al. Self-obtained vaginal swabs are not inferior to provider-performed endocervical sampling for emergency department diagnosis of Neisseria gonorrhoeae and Chlamydia […]




























